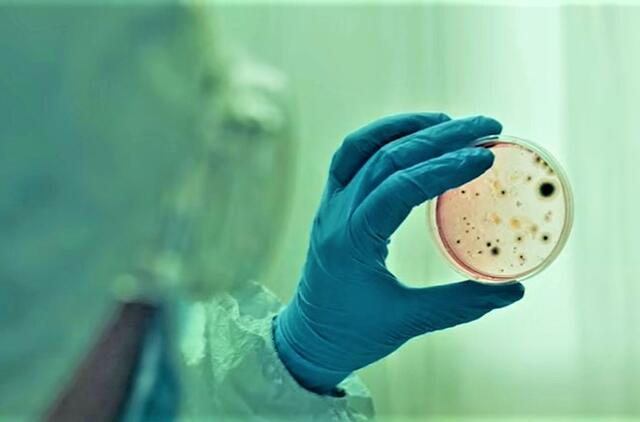

Mokslininkai teigė, kad šis sukėlėjas nesukėlė nė vieno mirties atvejo, tačiau 2018-2021 m. buvo aptiktas 35 nesusijusiems karščiuojantiems pacientams Šandongo ir Henano provincijų ligoninėse - tai atitinka ilgalaikius mokslininkų perspėjimus, kad gyvūnų virusai reguliariai nepastebimai plinta tarp žmonių visame pasaulyje.
"Mes labai nuvertiname šių zoonozių atvejų skaičių pasaulyje, ir šis (Langya virusas) yra tik ledkalnio viršūnė", - sakė naujų virusų ekspertas Leo Poonas, Honkongo universiteto Visuomenės sveikatos mokyklos profesorius, nedalyvavęs naujausiame tyrime.
Pirmieji moksliniai tyrimai apie šį virusą, kuriuos praėjusią savaitę žurnale "New England Journal of Medicine" kaip susirašinėjimą paskelbė Kinijos ir tarptautinių tyrėjų komanda, sulaukė pasaulinio dėmesio dėl padidėjusio susirūpinimo dėl ligos protrūkių.
Kasdien pasaulyje vis dar pranešama apie šimtus tūkstančių naujų Covid-19 atvejų, praėjus beveik trejiems metams nuo tada, kai Kinijoje pirmą kartą buvo aptiktas naujas pandemiją sukėlęs koronavirusas.
Tačiau tyrėjai teigia, kad nėra įrodymų, jog Langya virusas plinta tarp žmonių ar kad jis sukėlė vietinį susijusių atvejų protrūkį.
Jie pridūrė, kad norint paneigti, jog virusas plinta nuo žmogaus žmogui, reikia atlikti daugiau tyrimų su didesniu pacientų skaičiumi.
Naujų užkrečiamųjų ligų veteranė Linfa Vang (Linfa Wang), kuri priklausė tyrimų grupei, CNN sakė, kad nors mažai tikėtina, jog naujasis virusas išsivystys į "dar vieną "X ligos" atvejį", pavyzdžiui, anksčiau nežinomą patogeną, kuris sukels epidemiją ar pandemiją, "tai rodo, kad tokie zoonozės plitimo atvejai pasitaiko dažniau, nei mes manome ar žinome".
Norint sumažinti riziką, kad atsirandantis virusas taps sveikatos krize, "būtina vykdyti aktyvią priežiūrą skaidriai ir bendradarbiaujant tarptautiniu mastu", - sakė Djuko ir Singapūro nacionalinio universiteto Medicinos mokyklos profesorius Vangas.
Naujo viruso sekimas
Remiantis tyrėjų dokumentais, pirmosios užuominos apie naują virusą pasirodė, kai 2018 m. gruodžio mėn. 53 metų ūkininkas kreipėsi į Šandongo provincijos Čingdao miesto ligoninę dėl tokių simptomų kaip karščiavimas, galvos skausmas, kosulys ir pykinimas.
Kadangi pacientė nurodė, kad per pastarąjį mėnesį turėjo kontaktų su gyvūnais, ji buvo įtraukta į papildomą atrankinę patikrą, atliekamą trijose Rytų Kinijos ligoninėse, orientuotą į zoonozinių ligų nustatymą.
Ištyrę šios pacientės tyrimų mėginius, mokslininkai aptiko kai ką netikėto - niekada anksčiau nematytą virusą, susijusį su Hendra ir Nipah virusais, labai mirtinais patogenais iš šeimos, kuri paprastai nėra žinoma dėl lengvo plitimo nuo žmogaus žmogui.
Per kitus 32 mėnesius mokslininkai trijose ligoninėse tikrino, ar šis virusas nėra panašių pacientų, ir galiausiai jį aptiko 35 žmonėms, kuriems, be karščiavimo, pasireiškė įvairūs simptomai: kosulys, nuovargis, galvos skausmas ir pykinimas.
Devyni iš šių pacientų taip pat buvo užsikrėtę žinomais virusais, pavyzdžiui, gripu, todėl jų simptomų šaltinis buvo neaiškus, tačiau tyrėjai mano, kad likusių 26 pacientų simptomus galėjo sukelti naujasis henipavirusas.
Kai kuriems iš jų pasireiškė sunkūs simptomai, pavyzdžiui, plaučių uždegimas arba trombocitopenijos, trombocitų būklės, sutrikimai, tačiau, pasak Wang, jų simptomai buvo toli gražu nepanašūs į tuos, kurie pasireiškė Hendra arba Nipah virusu sergantiems pacientams, ir nė vienas iš šios grupės pacientų nemirė arba nebuvo paguldytas į intensyvios terapijos skyrių.
Nors visi pasveiko, jie nebuvo stebimi dėl ilgalaikių problemų, pridūrė jis.
Iš 26 asmenų grupės visi, išskyrus keturis, buvo ūkininkai, ir nors kai kurie iš jų buvo užregistruoti toje pačioje ligoninėje kaip ir pirminis aptiktas atvejis, daugelis kitų buvo aptikti Sinjango mieste, esančiame už daugiau nei 700 km. Henano provincijoje.
Kadangi buvo žinoma, kad panašūs virusai cirkuliuoja tarp gyvūnų nuo pietvakarių Kinijos iki Pietų Korėjos, "nenuostabu", kad per tokį didelį atstumą virusas išplito tarp žmonių, paaiškino Wangas.
Wangas ir jo kolegos savo išvadose rašė, kad "tarp pacientų nebuvo jokio artimo kontakto ar bendro sąlyčio su žmogumi istorijos" ar kitų plitimo nuo žmogaus žmogui požymių.
Tai leidžia manyti, kad atvejai buvo pavieniai, tačiau, pasak jų, reikia atlikti daugiau tyrimų.
Sužinoję, kad žmonės užsikrėtė nauju virusu, tyrėjai, tarp kurių buvo Pekine dirbančių mokslininkų ir Čingdao ligų kontrolės pareigūnų, ėmėsi darbo, kad išsiaiškintų, kuo užsikrėtė pacientai.
Jie ištyrė naminius gyvūnus, su kuriais gyveno ligoniai, ieškodami ankstesnio užsikrėtimo šiuo virusu pėdsakų, ir rado nedidelį skaičių ožkų ir šunų, kurie anksčiau galėjo būti užsikrėtę šiuo virusu.
Tačiau tikrasis proveržis įvyko, kai buvo ištirti mėginiai, paimti iš mažų laukinių gyvūnų, sugautų spąstais, ir rasta 71 užsikrėtęs dviejų rūšių žvirblinių gyvūnų, todėl mokslininkai padarė prielaidą, kad šie maži, į graužikus panašūs žinduoliai gali būti natūralios viruso cirkuliacijos vieta.
Tačiau lieka neaišku, kaip virusas pateko į žmonių organizmą, sakė Wangas.
Jis sakė, kad tolesni tyrimai, kurių metu būtų tikrinamas Langya henipavirusas, turėtų būti atliekami ne tik dviejose provincijose, kuriose buvo aptiktas virusas, bet ir plačiau Kinijoje bei už jos ribų.
Kinijos nacionalinė sveikatos komisija iš karto neatsakė į prašymą pakomentuoti, ar vykdoma naujų užsikrėtimo šiuo virusu atvejų stebėsena.
Rizikos mažinimas

Manoma, kad pasaulyje 70 proc. naujų infekcinių ligų į žmones patenka per kontaktą su gyvūnais, o šis reiškinys, pasak mokslininkų, spartėja, nes žmonių populiacija plečiasi į laukinės gamtos buveines.
Per pastaruosius du dešimtmečius Kinijoje kilo dideli naujų virusų protrūkiai, įskaitant 2002-2003 m. SARS ir Covid-19, kurie pirmą kartą buvo aptikti šalyje ir kuriuos sukėlė, kaip manoma, šikšnosparnių platinami virusai.
Pražūtingi abiejų ligų padariniai, ypač Covid-19, nuo kurio iki šiol pasaulyje mirė daugiau kaip 6,4 mln. žmonių, rodo, kaip svarbu greitai nustatyti naujų virusų atvejus ir dalytis informacija apie galimą pavojų.
Mokslininkai teigia, kad reikia atsakyti į svarbiausius klausimus, kaip plačiai naujasis virusas gali būti paplitęs gamtoje, kaip jis plinta tarp žmonių ir kiek jis pavojingas žmonių sveikatai, įskaitant galimybę jam plisti tarp žmonių arba įgyti tokį gebėjimą, jei jis ir toliau iš gyvūnų pateks tarp žmonių.

Rašyti komentarą